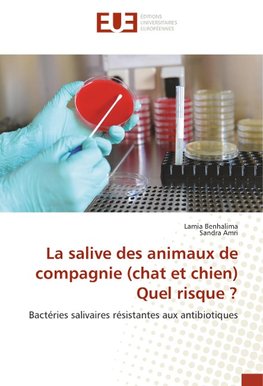
La salive des animaux de compagnie (chat et chien) Quel risque ?

-
 Francúzsky jazyk
Francúzsky jazyk
La salive des animaux de compagnie (chat et chien) Quel risque ?
Autor: Lamia Benhalima
La salive du chat est considérée comme étant la salive la plus toxique, suivie par celle des chiens, ce sont les bactéries présentes naturellement dans cette sécrétion qui sont responsables de leur toxicité. La présente étude synthétise les données bibliographiques... Viac o knihe
Na objednávku
53.68 €
bežná cena: 56.50 €
O knihe
La salive du chat est considérée comme étant la salive la plus toxique, suivie par celle des chiens, ce sont les bactéries présentes naturellement dans cette sécrétion qui sont responsables de leur toxicité. La présente étude synthétise les données bibliographiques des principales maladies transmissibles à l'homme via la salive des animaux de compagnie, comme elle confirme, par une étude expérimentale, la présence des bactéries pathogènes antibio-résistantes dans la sécrétion salivaire des chats et des chiens domestiques.
- Vydavateľstvo: Éditions universitaires européennes
- Rok vydania: 2019
- Formát: Paperback
- Rozmer: 220 x 150 mm
- Jazyk: Francúzsky jazyk
- ISBN: 9786139514250

 Anglický jazyk
Anglický jazyk 










